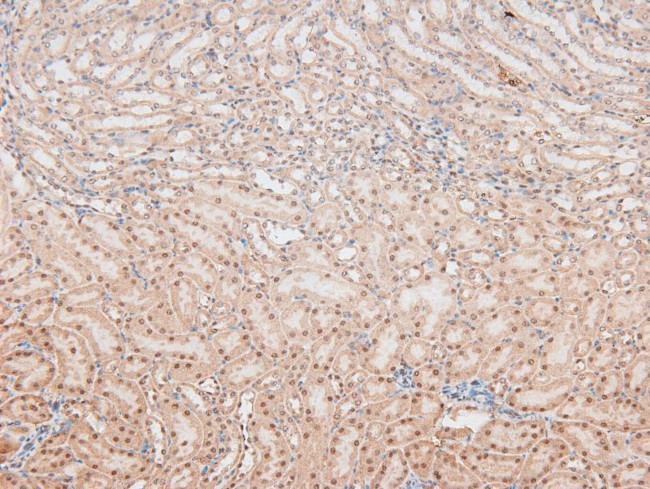
Phospho-Caspase 8 (Tyr448) Antibody in Immunohistochemistry (Paraffin) (IHC (P))

Search
Invitrogen
Phospho-Caspase 8 (Tyr448) Polyclonal Antibody
{{$productOrderCtrl.translations['antibody.pdp.commerceCard.promotion.promotions']}}
{{$productOrderCtrl.translations['antibody.pdp.commerceCard.promotion.viewpromo']}}
{{$productOrderCtrl.translations['antibody.pdp.commerceCard.promotion.promocode']}}: {{promo.promoCode}} {{promo.promoTitle}} {{promo.promoDescription}}. {{$productOrderCtrl.translations['antibody.pdp.commerceCard.promotion.learnmore']}}
图: 1 / 4
Phospho-Caspase 8 (Tyr448) Antibody (PA5-105841) in IHC (P)




Please note: We are reviewing Western blot images included in the antibody testing data in our catalog, including those provided by third parties. Unless expressly labeled or annotated as “raw-unedited”, Western blot images included in the antibody testing data in our catalog may have been edited, optimized or otherwise adjusted for presentation.
产品信息
PA5-105841
种属反应
宿主/亚型
分类
类型
抗原
偶联物
形式
浓度
规格
纯化类型
保存液
内含物
保存条件
运输条件
RRID
产品详细信息
Antibody detects endogenous levels of Caspase 8 only when phosphorylated at Tyr448.
靶标信息
Caspase 8 (CASP8) is a member of the cysteine-aspartic acid protease (caspase) family. Sequential activation of caspases play a central role in the execution-phase of cell apoptosis. Caspases exist as inactive proenzymes composed of a pro-domain, a large protease subunit, and a small protease subunit. Activation of caspases requires proteolytic processing at conserved internal aspartic residues to generate a heterodimeric enzyme consisting of the large and small subunits. Caspase 8 is involved in the programmed cell death induced by Fas and various apoptotic stimuli. The N-terminal FADD-like death effector domain of Caspase 8 suggests that it may interact with Fas-interacting protein FADD. Caspase 8 was detected in the insoluble fraction of the affected brain region from Huntington disease patients but not in those from normal controls, which implicated the role in neurodegenerative diseases. Caspase 8 binds to the death effector domain (DED) of FADD through an analogous DED domain present in tandem in the pro-form of the Caspase 8 protein. Activated Caspase 8 then activates other downstream caspases including Caspase 9, thereby committing the cell to undergo apoptosis. In addition, Caspase 8 also reacts with Jurkat cells and Tonsil. Overexpression of Caspase 8 induces apoptosis, which can be blocked by inhibitors specific for the ICE family. Many alternatively spliced transcript variants encoding different isoforms have been described for Caspase 8, however, not all variants have had their full-length sequences determined.
仅用于科研。不用于诊断过程。未经明确授权不得转售。
篇参考文献 (0)
生物信息学
蛋白别名: Apoptotic cysteine protease; Apoptotic protease Mch-5; CAP4; CASP-8; Caspase-8; Caspase-8 precursor; Caspase8; EC 3.4.22.61; FADD-homologous ICE/ced-3-like protease; FADD-like ICE; Fas-linked ICE-like protease; FLICE; FLJ17672; ICE-like apoptotic protease 5; ICE8; MACH; MGC78473; MORT1-associated ced-3 homolog; OTTHUMP00000163720; OTTHUMP00000165063; OTTHUMP00000206557; OTTHUMP00000206581
基因别名: CASP-8; CASP8; FLICE; MACH; MCH5
UniProt ID: (Rat) Q9JHX4, (Mouse) O89110
Entrez Gene ID: (Rat) 64044, (Mouse) 12370